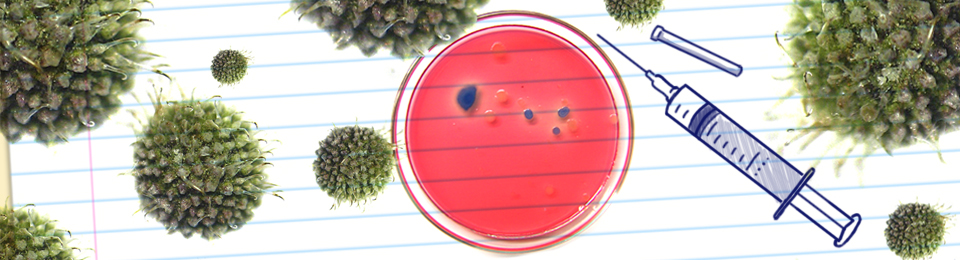
Qual a melhor formação para alguém que quer desenvolver vacinas?

Qual a melhor formação para alguém que quer desenvolver vacinas?
Orientador profissional esclarece
Quero dedicar minha vida na pesquisa e desenvolvimento de vacinas/antibióticos para animais, mas não sei qual curso escolher. Andei dando uma pesquisada na internet e acabei ficando ainda mais confuso. Biomedicina? Veterinária? Farmácia? Outra? Qual curso vocês recomendam para eu chegar ao meu objetivo?Enviado por Felipe
Há objetos de trabalho na sociedade que recebem contribuições de diferentes profissionais de muitas áreas. Por exemplo: o atendimento de pessoas com necessidades especiais pode receber a atenção especializada de pedagogos, psicólogos, fonoaudiólogos, médicos, terapeutas ocupacionais. A produção de produtos de higiene e limpeza recebe a contribuição de químicos, farmacêuticos, engenheiros químicos.
De fato, as profissões já pesquisadas por você permitem atingir seus objetivos – desenvolvimento de vacinas e medicamentos para animais, como Biomedicina, Farmácia, Medicina Veterinária, Ciências Biológicas (bacharelado) e Biotecnologia.
Os centros acadêmicos de pesquisa (universidades), órgãos, institutos e fundações públicos e empresas privadas costumam manter em seus quadros uma equipe multiprofissional de forma a complementar o conhecimento específico de cada profissional para melhor atingir os objetivos e garantir o domínio de todas as etapas do processo de desenvolvimento dos produtos indicados.
Não há uma “melhor formação” a indicar. O que você deve fazer é pesquisar as grades curriculares de cada curso para ver com qual(is) mais se identifica. Ao mesmo tempo considere outros elementos como remuneração média, áreas de especialização e conjunto geral de atribuições específicas de cada profissão para além daquelas desejadas por você (pois você terá que aprendê-las durante a graduação e ao mesmo tempo poderá exercê-las de forma complementar ou mesmo caso a inserção no mercado não ocorra da maneira desejada). De forma geral, para realizar pesquisas científicas há a necessidade de aprofundamento em cursos de pós-graduação stricto-sensu (mestrado e doutorado).
Você também pode tentar visitar órgãos e empresas que desenvolvem pesquisas neste setor e entrevistar profissionais das variadas formações para mais detalhamento.
Leia mais:
– Conheça os 23 cursos da área de Saúde
– Saiba como é a rotina dos veterinários





